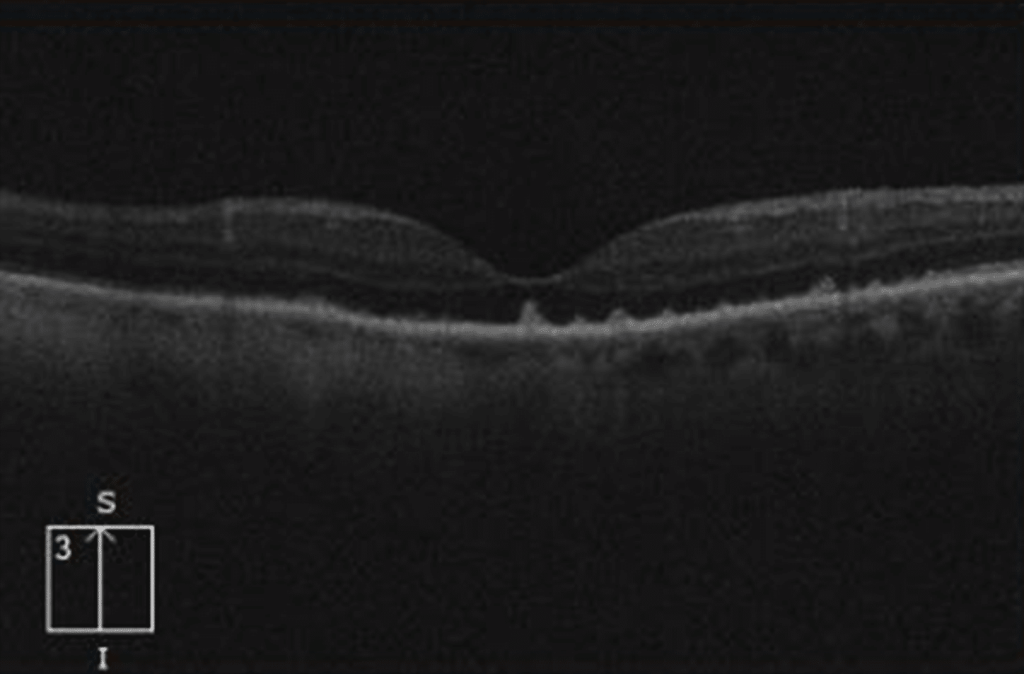

Uveítis sifilíticas, NO te olvides!!
Contents
La uveítis sifilítica es una manifestación ocular de la sífilis, una enfermedad infecciosa causada por la bacteria Treponema pallidum. Aunque la sífilis es una enfermedad conocida desde hace siglos, su capacidad para afectar múltiples sistemas del cuerpo, incluyendo los ojos, sigue siendo un tema de relevancia clínica. La uveítis, que se refiere a la inflamación de la úvea (la capa media del ojo, que incluye el iris, el cuerpo ciliar y la coroides), puede ser una complicación grave de la sífilis y requiere un diagnóstico y tratamiento oportunos para prevenir daños oculares irreversibles.

Epidemiología
La sífilis es una enfermedad de transmisión sexual que ha experimentado fluctuaciones en su incidencia a lo largo de la historia. Aunque la introducción de la penicilina en el siglo XX redujo significativamente su prevalencia, en las últimas décadas ha habido un resurgimiento de casos, particularmente en poblaciones con factores de riesgo como hombres que tienen sexo con hombres (HSH), personas con múltiples parejas sexuales y aquellos con infección por el virus de la inmunodeficiencia humana (VIH). Este aumento en la incidencia de sífilis ha llevado a un incremento paralelo en las complicaciones asociadas, incluyendo la uveítis sifilítica.
De hecho, en nuestro entorno, el mínimo histórico de sífilis se dio en los años 2000, desde entonces no ha hecho nada más que aumentar. Al tratarse de una enfermedad de declaración obligatoria, los datos poblacionales están disponibles a través del ministerio de Sanidad. Aproximadamente un 35-40% de los casos de uveitis sifilítica se encuentran asociados a VIH.

La uveítis sifilítica puede ocurrir en cualquier etapa de la sífilis, aunque es más común en las etapas secundaria y terciaria de la enfermedad.
Patogenia
La patogenia de la uveítis sifilítica está relacionada con la capacidad de Treponema pallidum para diseminarse a través del torrente sanguíneo y afectar múltiples órganos, incluyendo los ojos. La bacteria puede invadir los tejidos oculares, desencadenando una respuesta inflamatoria que conduce a la uveítis. En algunos casos, la inflamación puede ser el resultado de una reacción inmune mediada por complejos antígeno-anticuerpo, lo que contribuye al daño tisular.
Formas clínicas
La sífilis ocular puede manifestarse de diversas formas, incluyendo uveítis anterior, intermedia, posterior o panuveítis (afectación de toda la úvea). La uveítis anterior, que afecta el iris y el cuerpo ciliar, es la forma más común de uveítis sifilítica. Sin embargo, la inflamación también puede extenderse a la coroides y la retina, lo que puede resultar en complicaciones graves como desprendimiento de retina, edema macular y atrofia óptica.
Tal y como describen Furtado et al., la sífilis puede presentarse prácticamente como cualquier tipo de inflamación ocular, desde escleritis hasta neuroretinitis, por lo que siempre tendremos que tener esta etiología en mente.
Existen 3 presentaciones en las que siempre deberemos considerar la sífilis dentro del diagnóstico diferencial. Además de la necrosis retiniana aguda periférica, nos podemos encontrar con las dos presentaciones que describimos a continuación.
Coroidopatía placoide sifilítica aguda
Esta entidad se caracteriza por una lesión hipopigmentada macular (bilateral o unilateral) relativamente tenue. Si observamos el fondo de ojo con mucho aumento, esta lesión puede pasar desapercibida.

En el OCT típicamente veremos proyecciones en forma de «dedo» desde las capas más externas de la retina hacia capas más internas.
En la autofluorescencia suele observarse una lesión más o menos redondeada hiperautofluorescente con una corona aún más hiperauto.

Retinitis periférica
Esta lesión suele presentarse de forma bilateral, típicamente en sectores temporales o nasales, en forma de triángulo blanquecino. Sobre esta lesión, que algunos autores describen como en «cristal esmerilado» aparecen lesiones puntiformes blanquecinas que afectan a capas más superficiales de la retina.

Diagnóstico
El diagnóstico de la uveítis sifilítica requiere un alto índice de sospecha, especialmente en pacientes con factores de riesgo para sífilis. La evaluación inicial debe incluir una historia clínica detallada, con énfasis en los antecedentes sexuales y la presencia de síntomas sistémicos de sífilis, como erupciones cutáneas, fiebre o linfadenopatía.
Las pruebas diagnósticas para la sífilis incluyen:
- Pruebas no treponémicas: Estas pruebas, como la VDRL (Venereal Disease Research Laboratory) y la RPR (Rapid Plasma Reagin), detectan anticuerpos no específicos que se producen en respuesta a la infección por Treponema pallidum. Aunque son útiles para el cribado, pueden dar resultados falsos positivos en ciertas condiciones, como enfermedades autoinmunes o infecciones virales.
- Pruebas treponémicas: Estas pruebas, como la FTA-ABS (Fluorescent Treponemal Antibody Absorption) y la TP-PA (Treponema pallidum Particle Agglutination), detectan anticuerpos específicos contra Treponema pallidum y son más específicas que las pruebas no treponémicas. Un resultado positivo en una prueba treponémica confirma la exposición a la bacteria.
El algoritmo directo se basa en realizar primero las pruebas no-treponémicas, para hacer las treponémicas en caso de que resulten positivas. El abordaje inverso, al alza en los últimos años, propone un protocolo en el orden contrario.
En casos de uveítis sifilítica, tanto la CDC americana como las diferentes sociedades europeas recomiendan el abordaje del paciente asumiendo que se trata de una neurosífilis.
Tratamiento
El tratamiento de la uveítis sifilítica se basa en la erradicación de Treponema pallidum con antibióticos y el control de la inflamación ocular. El tratamiento estándar para la sífilis es la penicilina, que sigue siendo el antibiótico de elección debido a su eficacia contra Treponema pallidum.
Dada la situación de neurosífilis, el tratamiento es más agresivo que en sus formas sin afectación del sistema nervioso central. En este caso, el tratamiento se realiza con Penicilina G sódica 4 millones DUI endovenosa cada 4 horas durante 10-14 dias
En pacientes alérgicos a la penicilina, se pueden utilizar alternativas como la doxiciclina o la ceftriaxona, aunque la penicilina sigue siendo el tratamiento preferido y se recomienda la desensibilización del paciente a la penicilina.
Además del tratamiento antibiótico, el manejo de la uveítis sifilítica puede requerir el uso de corticosteroides tópicos o sistémicos para controlar la inflamación ocular. En casos graves, pueden ser necesarios inmunosupresores o terapia biológica.
Pronóstico
El pronóstico de la uveítis sifilítica depende de la prontitud del diagnóstico y el tratamiento. Con un tratamiento adecuado, la mayoría de los pacientes experimentan una resolución de la inflamación y una mejora en la agudeza visual. Sin embargo, en casos de diagnóstico tardío o tratamiento inadecuado, pueden ocurrir complicaciones como glaucoma, catarata, desprendimiento de retina o atrofia óptica, lo que puede resultar en pérdida permanente de la visión.
Como verán, el retraso en el diagnóstico debido al error diagnóstico inicial, supone el mayor factor predictivo de baja agudeza visual final.

Conclusión
La uveítis sifilítica es una manifestación ocular grave de la sífilis que requiere un diagnóstico y tratamiento oportunos para prevenir complicaciones visuales irreversibles. Los oftalmólogos y los médicos en general deben mantener un alto índice de sospecha en pacientes con uveítis, especialmente aquellos con factores de riesgo para sífilis. El tratamiento con penicilina sigue siendo la piedra angular del manejo, y el control de la inflamación ocular es esencial para preservar la visión. Con un enfoque multidisciplinario que incluya oftalmólogos, infectólogos y médicos de atención primaria, es posible mejorar los resultados en pacientes con uveítis sifilítica y reducir la carga de esta enfermedad en la población.
Bibliografía
- Oliver, G. F. et al. Current ophthalmology practice patterns for syphilitic uveitis. Br J Ophthalmol 103, 1645–1649 (2019).
- Furtado, J. M. et al. Clinical Manifestations and Ophthalmic Outcomes of Ocular Syphilis at a Time of Re-Emergence of the Systemic Infection. Sci Rep 8, 12071 (2018).
- Ministerio de Sanidad. Vigilancia epidemiológica de las infecciones de transmisión sexual en España, 2022. (2024).